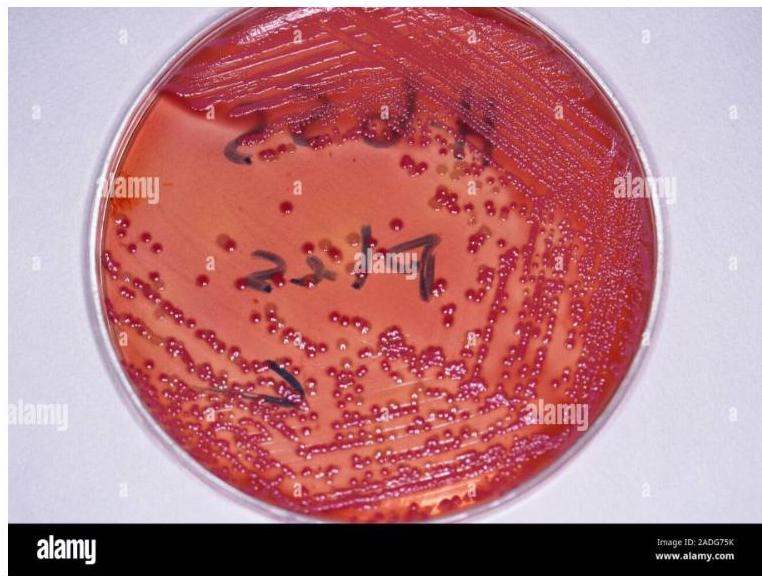
img-37.jpeg

Pulmonary Tuberculosis
Prepared by: Dr. Salma ElGazzar

Etiology and Bacteriology
Mycobacterium tuberculosis: The Causative Agent
Mycobacterium tuberculosis, known as the tubercle bacillus, is the primary causative agent of tuberculosis. Its unique characteristics make diagnosis and treatment challenging.
Bacterial Characteristics
- Morphology: Curved rod-shaped morphology.
- Dimensions: Measures 0.2–0.5 µm by 2–4 µm.
- Physiology: Aerobic, non-spore-forming organism; non-motile, facultative intracellular rod.
- Staining: The bacterium retains many stains after decolorization with acid-alcohol, forming the basis of acid-fast stains used for pathological identification — a crucial diagnostic feature.

Types of Mycobacterium
- Human Bacillus: Causes pulmonary tuberculosis and 50% of intestinal TB cases. It is the most common form affecting humans worldwide.
- Bovine Bacillus: Responsible for the other 50% of intestinal TB. Sterilization of milk effectively kills this organism.
- Other Types: Avian, murine, and vole bacilli rarely affect humans but may cause disease in immunocompromised patients.
Epidemiology and Transmission
Transmission Pathways
1. Airborne Transmission (Most Common)
Inhalation of droplets or dust particles is the primary route. Entry occurs through the lungs or tonsils. TB spreads easily from infected adults to children in households or childcare centers.
2. Ingestion Route
Entry occurs through tonsils or intestines via contaminated food or water. This is less common but significant in areas with poor sanitation.
3. Wound Infection
Occurs in handlers of infected material through skin entry. This poses an occupational risk for healthcare workers and laboratory personnel.
Important Note: TB is unlikely to spread from children under 4 years of age due to limited tussive (coughing) force.


Primary Sites of Infection
-
Lungs: The most common primary site, accounting for up to 80% of all tuberculosis infections. Pulmonary TB presents with respiratory symptoms and characteristic radiographic findings.
-
Intestines: Primary site for bovine tuberculosis through ingestion of contaminated dairy products. Less common with pasteurization.
-
Tonsils: Secondary entry point through airborne transmission or ingestion. Can lead to cervical lymphadenopathy and systemic spread.
-
Skin: Entry point for wound infections in healthcare workers and laboratory personnel handling infected materials.
Risk Factors for Tuberculosis
High-Risk Populations and Conditions
- Immunocompromising Conditions:
- HIV infection.
- TNF-alpha antagonist treatment (infliximab, etanercept).
- Other immunosuppressive conditions (congenital or acquired).
- Medical Conditions:
- Recent latent tuberculosis infection (LTBI).
- Diabetes mellitus.
- Renal failure / Chronic kidney failure.
- Malnutrition.
- Malignancies (e.g., Hodgkin disease, lymphoma).
- Behavioral & Environmental Factors:
- IV drug use / Substance abuse.
- Repeated exposure to infection.
- Low body resistance in unimmunized individuals.
- Employment at a health care facility, homeless shelter, or prison.
- Living with someone infected with TB.
- Travel to areas where TB is common.

Pathophysiology and Immunology
Disease Progression Timeline
- Initial Exposure: Contact with infectious TB case through airborne droplets or other transmission routes.
- Incubation Period (2–10 Weeks): Time from exposure to development of a positive TST or IGRA result.
- High Risk Period (First 12 Months): Risk of developing active TB disease is highest during the first 12 months after infection.
- Long-term Risk: Risk remains elevated for 2 years, but many years can elapse before disease development.

Cell-Mediated Immune Response
The immune response to tuberculosis infection is primarily cell-mediated, creating a distinctive hypersensitivity reaction to mycobacterial antigens. This response is a double-edged sword: while it attempts to contain the infection, it simultaneously causes significant tissue damage.
- Caseating Granulomas: Formation of characteristic granulomatous inflammation with central necrosis.
- Tissue Destruction: Progressive damage to lung parenchyma and surrounding structures.

Primary Infection: The Ghon Focus
Although primary infection most commonly occurs in the lung, it may also involve other organs including lymph nodes, bones and joints, the genitourinary system, and the meninges.

1. Initial Site Selection
The Ghon focus typically develops in the lower part of an upper lobe or upper part of a lower lobe — regions of greatest airflow where inhaled bacilli are most likely to deposit.
2. Subpleural Location
The primary infection site is usually subpleural, often causing a small pleural effusion as the inflammatory process extends to the pleural surface.
3. Lymph Node Involvement (The Primary Complex)
The local host response may fail to contain inhaled M. tuberculosis, allowing spread via the lymphatic system to regional lymph nodes. The lung lesion plus the lymph node constitutes the ‘Ghon (or primary) complex’.
- Enlarged peribronchial lymph nodes may cause bronchial compression/obstruction and distal atelectasis, leading to collapse and consolidation of affected lung segments.
4. Healing Process
Most cases of primary tuberculosis heal at this stage, leaving only a small fibrocalcific scar in the lung and mediastinum (Ranke complex), sometimes visible on chest x-ray.
(b) Chest X-ray of pulmonary TB. There is marked left hilar lymphadenopathy.
Disease Progression: When Containment Fails
When the primary complex cannot be contained, tuberculosis can spread through multiple pathways:
-
Lymphatic & Bronchial Spread: Spread along the lymphatics or via the bronchi can result in tuberculous bronchopneumonia, causing widespread pulmonary involvement.
-
Hematogenous Dissemination: Bacilli gain access to the bloodstream. Outcomes depend on bacterial load and host immune status:
-
Subacute Dissemination: Lower bacterial loads lead to isolated organ tuberculosis (kidneys, bones, CNS).
-
Miliary Tuberculosis: High bacterial loads result in widespread dissemination creating multiple small lesions throughout the body.
-

Latent vs. Active Tuberculosis
Latent Tuberculosis (LTBI)
- Definition: Asymptomatic stage of M. tuberculosis infection.
- Findings: Positive TST or IGRA but normal chest radiograph (or signs of healed infection with calcification).
- Dormancy: Both asymptomatic and symptomatic infections may become dormant.
Active Tuberculosis Disease
- Definition: Clinical signs and symptoms present.
- Findings: Abnormal chest radiograph or extrapulmonary manifestations.
- Reactivation (Post-primary TB): Dormant infection can reactivate and spread by lymphohaematological routes. The interval from latent to active disease varies from weeks in children to decades in adults.

Clinical Manifestations
Clinical features of tuberculosis.
Primary Tuberculosis in Children
Asymptomatic Presentation
Nearly half of infants and 90% of older children have minimal or no symptoms.
- Manifestations: Positive TST or IGRA with mild chest radiograph abnormalities (atelectasis, infiltrate, hilar adenopathy, Ghon complex).
- Management: Asymptomatic children with a positive TST (Fig. 15.21a) or IGRA should be given chemoprophylaxis to prevent future conversion to active TB.
(a) Example of a positive TST (24-mm induration).
Symptomatic Presentation
Systemic symptoms develop when the host’s cellular immune system responds to infection (3–6 weeks):
- Fever
- Anorexia and weight loss
- Cough
- Chest X-ray changes
Note: The distinction between infection and disease may be less obvious in young children, as TB usually develops as an immediate complication of primary infection.
Pediatric chest x-ray showing hilar lymphadenopathy tuberculosis.

Progression Stages
- Ghon Focus: Tuberculoma.
- Ghon Complex: Tuberculoma + Hilar Lymph Node Adenopathy (Not visible without calcification).
- Ranke Complex: Visible calcified complex.
Progressive Primary Disease
Characterized by primary pneumonia that develops shortly after initial infection.
- Represents a more severe form of tuberculosis in children.
- Risk: Progression to disseminated miliary disease or CNS infection occurs most commonly in the first year of life.
- Cavitation: Rare in children (unlike adults).
Reactivation Pulmonary Tuberculosis
Typically occurs in adolescents and adults.
1. Location Pattern
Usually confined to the apical segment of upper lobes or superior segments of lower lobes, representing secondary expansion of infection at previously seeded sites.
2. Clinical Features
- Lymphadenopathy: Little lymphadenopathy (distinguishes it from primary TB). -
- Cavitation: Associated with cavitation and endobronchial spread of bacilli.
3. Symptoms
-
Constitutional Symptoms: Fever, night sweats, malaise, and significant weight loss characterize the systemic response to reactivation tuberculosis.
-
Respiratory Symptoms: Productive cough and hemoptysis often herald cavitation and bronchial erosion, indicating advanced disease progression.


Age-Related Clinical Differences Summary
- Infants and adolescents: More likely to be symptomatic.
- Children 5–10 years: Often asymptomatic or mild symptoms.
- Disease progression: Only 5–10% of children >3 years with untreated LTBI progress to disease.
Delayed Hypersensitivity Symptoms Z
- Low-Grade Fever: Persistent mild elevation following hypersensitivity response.
- Erythema Nodosum: Painful red nodules, typically on the shins; an inflammatory response to infection.

- General Malaise: Discomfort/fatigue accompanying immune response.
- Lymph Node Enlargement: Compression symptoms.
Differential?
2 drugs 2 infetions 2 collagen diseases
Extrapulmonary Tuberculosis

1. Tuberculous Pleural Effusion
May accompany primary infection; generally represents immune response rather than direct invasion. Most common in older children or adolescents.
- Imaging: Homogenous density, loculated, loss of cardio-phrenic angle and lateral diaphragmatic silhouette.

- Pleurocentesis Findings:
- Lymphocyte predominance.
- Increased protein levels.
- Usually no bacilli present in pleural fluid (culture often negative).
2. Superficial Lymphadenopathy (Extrathoracic Lymphadenitis)
- Prevalence: Most common extrapulmonary form.
- Presentation: Nodes measure 2–4 cm, lack inflammatory findings. Common in anterior cervical, supraclavicular, and submandibular regions.
3. Miliary Tuberculosis
- Definition: Widespread hematogenous dissemination to multiple organs; lesions resemble millet seeds.
- Risk: Young/immunocompromised patients.
- Presentation: Fever, general malaise, weight loss, lymphadenopathy, night sweats, hepatosplenomegaly, diffuse bilateral pneumonitis.
- Diagnostics: TST may be nonreactive due to anergy. A live or bone marrow biopsy may be useful for diagnosis when other methods fail.
Chest x-ray showing diffuse bilateral opacities.
4. Tuberculous Meningitis
Most commonly occurs in children <5 years or immunocompromised patients, often within 6 months of primary infection.
- Pathophysiology: Tubercle bacilli seed the meninges during primary infection, replicate, and trigger inflammatory response leading to basilar meningitis.
- Clinical Progression:
- Insidious onset with low-grade fever.
- Headache and subtle personality changes.
- Cranial nerve impingement.
- Increased intracranial pressure.
- Mental status deterioration and coma.
- CT Findings: Hydrocephalus, cerebral edema, periventricular lucencies, infarctions.
- CSF Analysis: OSPE
- Pleocytosis (50–500 leukocytes/mm³).
- Low glucose, significantly elevated protein.
- Acid-fast bacilli rarely detected.
- Diagnosis: Culture (gold standard), PCR (faster but less sensitive).
- Lumbar Puncture: Performed below L2 (L3–L4 or L4–L5) in order not to injure the spinal cord.




5. Skeletal Tuberculosis
- Sites: Spine (Pott disease - most common), arthritis, osteomyelitis.
- Presentation: Chronic disease with insidious onset; can develop >10 years after infection. May be mistaken for chronic osteomyelitis.
- Diagnostics: Radiographs show cortical destruction, vertebral collapse, disk space narrowing. Biopsy/culture essential.

6. Other Forms
- Abdominal Tuberculosis: From swallowing infected material. Tuberculous peritonitis presents with fever, anorexia, ascites, abdominal pain. Mimics inflammatory bowel disease.
- Urogenital Tuberculosis: Late reactivation complication (rare in children). Dysuria, frequency, hematuria, sterile pyuria, infertility.
- CNS Tuberculomas: Occur in 5% of CNS TB cases.
- Extrathoracic Lymphadenitis: TB may result in lymphadenitis in cervical, supraclavicular, and submandibular areas.
Congenital Tuberculosis
- Presentation: May mimic neonatal sepsis with nonspecific symptoms. Z
- Key Features: Presents at days to weeks of age with hepatosplenomegaly and respiratory disease.

Diagnosis
Diagnostic Imaging Findings
Radiography is the cornerstone for diagnosis in children.
Pulmonary Findings
- All lobar segments equally at risk.
- Hilar/Mediastinal Adenopathy: Most common abnormal finding; often the only visible abnormality in early disease.
- Parenchymal: Infiltrates, atelectasis (due to bronchial obstruction), consolidation.
- Advanced: Cavitation (rare in children), miliary pattern.
Radiography is cornerstone for diagnosis in children due to clinically silent presentations. All lobar segments equally at risk for initial infection. • 25% of cases involve two or more lobes • Hilar lymphadenopathy inevitably present • Partial bronchial obstruction causes air trapping • Progressive destruction leads to cavitation
Plain radiographs, CT, and MRI aid greatly in extrapulmonary TB diagnosis. Spinal TB shows vertebral collapse and disk space narrowing. Bone and joint TB ranges from mild effusions to massive destruction
Extrapulmonary Imaging
- Plain radiographs, CT, and MRI aid in diagnosis.
- Spinal TB: Vertebral collapse, disk space narrowing.

Diagnostic Imaging Findings Normal Chest X-ray Children with latent TB infection (LTBI) usually have normal-appearing chest radiographs. An isolated calcified lesion with positive TST can be treated as LTBI. Hilar/Mediastinal Adenopathy The most common abnormal radiographic finding in pediatric pulmonary TB. May be the only visible abnormality in early disease. Other Findings Infiltrates, atelectasis, pleural effusions, cavity lesions, or miliary disease pattern may be present in advanced cases.
Laboratory Diagnosis: Culture & Molecular
Culture (Gold Standard)
- Confirmation: Ultimate diagnosis relies on organism culture.
- Sample Collection:
- Sequential Sputum: Older children/adults.
- Gastric Aspiration: Early morning secretions in younger children (swallow sputum during sleep). Yield up to 50%.
- Induced Sputum: Alternative for pediatrics.
- Growth Characteristics: Slow growing.
- 6–8 weeks on Lowenstein-Jensen media.
- 2–3 weeks in liquid media.
Acid-Fast Staining
Common AFB stains include:
- Kinyoun stain.
- Auramine-rhodamine (Truant).
- Ziehl-Neelsen stain.
Molecular Diagnostics (PCR)
- Expedites diagnosis (especially CNS).
- Limited sensitivity; provides no susceptibility data. - Most experts recommend lumbar puncture for infants < 12 months with suspected TB.
Immunological Testing
Who Needs Tuberculosis (TB) Testing?
- Immediate Testing:
- Children in close contact with a confirmed or suspected TB case.
- Children with X-rays or other signs suggesting active TB disease.
- Children recently from or with significant travel to high TB prevalence countries (e.g., parts of Asia, Middle East, Africa, Latin America, former Soviet Union).
- Annual Testing: Children living with HIV.
- High Risk Indications:
- Children with weakened immune systems (Diabetes, Chronic kidney failure, Malnutrition, Congenital/Acquired immunodeficiency).
- Before starting immunosuppressive medications (e.g., long-term steroids, TNF antagonists, organ transplant therapies).
- Specific Risk Groups: Homeless/underhoused, elderly, lived on a reserve or Inuit community, resided/worked in a correctional facility or shelter system.

1. Tuberculin Skin Test (TST) / Mantoux Test
-
Target: Preferred for children < 2–4 years.
-
Method: Intradermal injection of 0.1 ml (5 tuberculin units) PPD-S.
- NICE Guidelines (UK, 2016): A TST (2 units PPD) is positive if the palpable induration is 5mm or more, irrespective of BCG history
TST

Administration Protocol
- Site Selection: Place forearm palm up. Select area 2–4 inches below elbow, free of scars, lesions, or wounds (“lattices”). Clean with alcohol swab.
- Preparation: Check tuberculin expiration date. Use a 1ml tuberculin syringe with a 1/2 inch 20 or 21 gauge needle. Withdraw 0.1 ml (5 tuberculin units). Administer immediately.
- Injection: Insert needle bevel up just below skin surface at a 5–10° angle. Inject to create a wheal (“school”) of 5mm.
- Verification: If 5mm wheal does not appear, repeat test 2–4 inches away.
- Documentation: Record arm (L/R), tuberculin lot number, expiration date, date/time administered, and signature.
Reading & Interpretation
-
Protocol: Measure induration (not erythema) perpendicular to forearm axis at 48–72 hours.
-
Positive Definition: Test is positive if induration meets criteria (even if read after 72 hours).
-
Reporting (Toronto Public Health):
- Positive TSTs AND suspect/confirmed TB cases must be reported to Toronto Public Health.
- Contact: TB Prevention and Control Program
- Note: TB medications for prophylaxis and treatment are FREE through public health.


Interpretation of Positive Results
| Induration Size | Risk Group / Significance |
|---|---|
| ≥ 5 mm | High Risk • Close contacts of contagious TB cases. • Clinical/Radiographic suspicion of TB. • Immunosuppressed (HIV, TNF antagonists, etc.). |
| ≥ 10 mm | Moderate Risk • Children < 4 years old. • Medical conditions (Diabetes, Renal failure, Lymphoma, Malnutrition). • Born in/travel to high-prevalence countries. • Exposed to high-risk adults (homeless, incarcerated, IV drug users). |
| ≥ 15 mm | Low Risk • Persons with no known risk factors (healthy >4 years). |
False Results
-
False-Negative (Anergy):
- Recent measles infection or vaccination
- High-dose corticosteroid treatment
- Irradiation therapy
- Immunosuppressive therapy
- Immunocompromising medical conditions
- Disseminated tuberculosis
-
False-Positive:
- Exposure to nontuberculous (environmental) mycobacteria
- Recent BCG vaccination
- Boosting phenomenon from multiple sequential
TSTs Key Point: Screen for exposure risk by history before testing. Do not test all children routinely.
2. Interferon-γ Release Assays (IGRA)
- Target: Recommended for persons > 2–4 years.
- Method: Whole blood test measuring INF-γ production by T lymphocytes.
- Advantages:
- Convenience Advantage: Only one office visit is required, eliminating the need for return visits to read results like TST
- No boosting phenomenon: There is no risk of the boosting phenomenon that can occur with multiple sequential TSTs.
- Higher Specificity: More specificity for LTBI because the antigens in IGRAs are shared less commonly with nontuberculous mycobacteria and are not found in BCG vaccine.
TST vs IGRA Comparison
| Characteristic | TST | IGRA |
|---|---|---|
| Age Preference | Children < 2–4 years | Persons > 2–4 years |
| BCG Interference | Cross-reaction possible | Unaffected by BCG |
| Visits Required | Two visits needed | Single visit sufficient |
| Timing | Positive 2–6 weeks post-infection | Similar sensitivity to TST |
| Specificity | Lower (BCG cross-reaction) | Higher specificity |
| Both tests may show indeterminate results in immunocompromised persons and active tuberculosis cases. |
Management and Prevention
TB Exposure Management Guidelines
- Children < 4 Years & Immunocompromised:
- Chest X-ray and TST immediately.
- Start prophylactic Isoniazid (INH) immediately, pending repeat testing.
- Repeat TST in 2–3 months. If negative, stop med. If positive, treat for LTBI.
- Children > 4 Years & Immunocompetent:
- Can be observed off medications pending second test result in 2–3 months.
Treatment Protocols Z

Latent TB Infection (LTBI)
- Mainstay: 12 weeks of daily INH and weekly rifampin.
- Alternative: 4 months of daily rifampin (for INH intolerant patients).
Active TB Disease
- Initial Phase (2 Months): INH + Rifampin + Pyrazinamide (PZA) + Ethambutol.
- Continuation Phase (4 Months): INH + Rifampin (Total duration 6 months).
- Stop: PZA and Ethambutol after 2 months if susceptible.
- Special Durations:
- TB Meningitis: 7–12 months.
- Miliary TB: 9–12 months.
Treatment protocols

Medication Side Effects & Monitoring
- Hepatotoxicity risk: INH, rifampin, and PZA can injure the liver → regular LFT monitoring required.
- **Optic neuritis: Ethambutol may rarely cause this; the first clue is decreased colour perception → urgent ophthalmologic review.
- Pyridoxine supplementation (indicated for): exclusively breast‑fed infants, nutritional deficiencies, symptomatic HIV patients, pregnant females.
Follow‑up protocol for children with TB
- Monthly visits should document:
- Medication tolerance & adherence
- Weight gain & growth trajectory
- Achievement of developmental milestones
- Laboratory monitoring for drug‑related side effects
Special clinical scenarios Z
-
Adult household member with infectious TB
- All children → chest radiograph and TST.
- Children < 4 yr → start empirical INH + rifampin; repeat TST in 2‑3 months.
-
Infant of a TB‑positive mother
- Mother with LTBI only → infant needs no evaluation.
- Mother with active TB → evaluate infant for congenital TB; keep infant separated until both receive appropriate therapy.
-
Healthcare workers
- Positive TST → obtain chest radiograph.
- Negative TST → may offer LTBI therapy after a risk‑benefit analysis.
- Positive TST → requires further evaluation.
Key takeaway
Early recognition, appropriate testing, and prompt treatment are essential for successful TB management in pediatric populations. Ongoing monitoring ensures treatment success and minimizes complications.
Prevention & control
- Case finding: TB control programs identify and treat cases to break secondary transmission.
- Infection control: BCG vaccine (attenuated M. bovis) provides 80‑90 % protection, reducing miliary disease and TB meningitis in infants.
- Healthcare screening: annual TST or IGRA for providers; contact investigations with timely treatment prevent spread.
Prognosis
With early detection and effective chemotherapy, children and adolescents have an excellent outlook, though drug‑resistant organisms pose growing challenges that demand specialized treatment approaches.